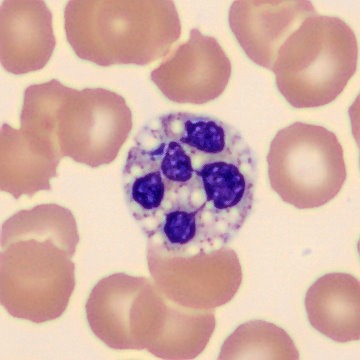

Hemograma na Sepse
A sepse é uma condição crítica caracterizada por uma resposta inflamatória descontrolada diante de uma infecção, capaz de comprometer rapidamente vários órgãos. A evolução depende tanto do microrganismo, bem como das condições do hospedeiro, como idade, imunidade, comorbidades e uso de medicamentos. Dessa forma, a identificação precoce das alterações laboratoriais é essencial para evitar a progressão para choque séptico e falência de múltiplos órgãos.
Os exames laboratoriais ajudam a detectar disfunção orgânica e a avaliar a intensidade da inflamação. Alterações nas séries branca, vermelha e plaquetária, associadas a parâmetros bioquímicos, refletem a gravidade do quadro.

Por que o hemograma importa na sepse
A sepse é entendida como uma disfunção orgânica causada por uma resposta imune desregulada. Em vez de controlar a infecção, o organismo libera mediadores inflamatórios em grande escala, comprometendo múltiplos sistemas. Sendo assim, como a evolução é rápida, a identificação precoce é decisiva.
Embora não confirme a infecção, o hemograma detecta de forma sensível as alterações típicas da resposta inflamatória sistêmica. Leucocitose, leucopenia, desvio à esquerda e trombocitopenia podem surgir antes da confirmação microbiológica, que muitas vezes é retardada por uso de antibióticos ou condições clínicas. Por isso, o hemograma é um exame simples, acessível e extremamente útil na avaliação inicial.
Leucócitos na sepse: o primeiro sinal
As alterações nos leucócitos costumam ser um dos primeiros indicadores de sepse. A leucocitose acima de 12.000 células por microlitro é comum em infecções bacterianas e reflete aumento da resposta imune. Por outro lado, a leucopenia abaixo de 4.000 células por microlitro também é relevante e está associada a maior gravidade e risco de mortalidade. Tanto o aumento quanto a redução importante dos leucócitos devem levantar suspeita de sepse.
Além disso, o aumento de bastonetes e granulócitos imaturos acima de 3 por cento indica estímulo medular intenso e forte correlação com infecções graves. A presença de vacuolização, grânulos tóxicos e corpúsculos de Döhle reforça a intensidade do processo infeccioso. Dessa forma, a combinação desses achados torna o hemograma uma ferramenta indispensável na suspeita inicial de sepse.
Linfócitos, plaquetas e eritrócitos: o que revelam sobre a sepse
A linfopenia é um achado muito frequente e indica impacto significativo da inflamação sobre a imunidade adaptativa. Valores abaixo de 800 células por microlitro aumentam o risco de evolução para choque séptico. Nos casos mais graves, a linfopenia tende a persistir. Já a recuperação dos linfócitos costuma acompanhar a melhora clínica. Ademais, esse comportamento está relacionado ao fenômeno de paralisia imunológica, resultado da ativação inflamatória prolongada.
As plaquetas também fornecem informações importantes. A trombocitopenia é comum e tem relação direta com a gravidade. Valores abaixo de 150.000 aumentam o risco de mortalidade. Reduções abaixo de 100.000 indicam maior comprometimento sistêmico, além disso, quedas menores que 50.000 costumam acompanhar disfunção orgânica múltipla. Esses achados refletem consumo plaquetário, ativação da coagulação, sequestro esplênico e lesão endotelial.
Embora menos discutidos, os eritrócitos também sofrem alterações na sepse. A queda do hematócrito ocorre por hemodiluição, hemólise discreta, redução da produção medular e efeitos da inflamação na eritropoiese. O aumento do RDW vem ganhando destaque como marcador sensível de gravidade, pois reflete estresse medular e instabilidade fisiológica.
Alterações simultâneas em diferentes linhagens são esperadas porque a sepse desencadeia ativação imunológica intensa, liberação de citocinas, disfunção medular, aumento do consumo periférico, coagulopatia e lesão endotelial. Esses mecanismos afetam todo o sistema hematológico e ajudam a estimar a gravidade do quadro.
Conclusão
O hemograma é uma ferramenta essencial na sepse, pois revela alterações rápidas e sensíveis que ajudam a identificar precocemente a gravidade do quadro. A análise conjunta das séries branca, vermelha e plaquetária orienta decisões imediatas e contribui para um manejo mais eficaz do paciente.
O próximo passo de todo analista que deseja ter mais segurança na bancada
Todo analista que busca se destacar e se tornar um profissional mais atualizado, capacitado e qualificado para o mercado de trabalho precisa considerar uma pós-graduação.
Um profissional com especialização é valorizado na área laboratorial; esse é um fato inegável.
Unimos o útil ao agradável ao desenvolver uma pós-graduação em Hematologia Laboratorial e Clínica.
Para aqueles que procuram a comodidade de uma pós-graduação 100% online e ao vivo, sem abrir mão da excelência no ensino, temos a solução ideal.
Nossa metodologia combina teoria e prática da rotina laboratorial, garantindo um aprendizado efetivo.
Contamos com um corpo docente altamente qualificado, com os melhores professores do Brasil, referências em suas áreas de atuação.
No Instituto Nacional de Medicina Laboratorial, temos apenas um objetivo: mais do que ensinar, vamos tornar VOCÊ uma referência.
Toque no botão abaixo e conheça a pós-graduação em Hematologia Laboratorial e Clínica.
QUERO CONHECER TODOS OS DETALHES DA PÓS-GRADUAÇÃO
Referências
HINDLMAYER, Maria Eduarda. Alterações hematobioquímicas em um paciente com sepse: relato de caso. 2022. Trabalho de Conclusão de Curso (Graduação em Medicina Veterinária) – Universidade Federal de Santa Catarina, Campus Curitibanos, Departamento de Agricultura, Biodiversidade e Florestas, Curitibanos, 2022.
MONNERAT, Mariana; SILVA, Líllian Oliveira Pereira da. Alterações do perfil hematológico em pacientes com sepse. Brazilian Journal of Health Review, Curitiba, v. 7, n. 9, p. 1–11, nov./dez. 2024.
SANTOS, Juliana Steffen dos. Análise do leucograma como preditor de mortalidade na infecção presumida e na sepse. 2019. 93 f. Dissertação (Mestrado em Saúde e Meio Ambiente) – Universidade da Região de Joinville – UNIVILLE, Joinville, 2019.



